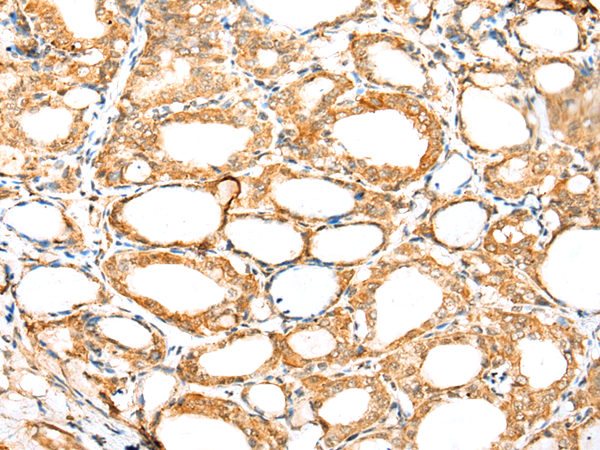

|
Background: |
Sm and Sm-like (LSm) proteins form donut-shaped, ubiquitously expressed heptameric complexes that are involved in various steps of RNA metabolism, including RNA-protein interactions and structural changes that are required during ribosomal subunit assembly. LSm11 is a 360 amino acid protein that localizes to the nucleus and belongs to the LSm subfamily of snRNP Sm proteins. Containing an N-terminal domain that is necessary for pre-mRNA cleavage, LSm11 functions to binds specifically to U7 snRNA and is thought to play a role in cell cycle regulation and cell growth. The gene encoding LSm11 maps to human chromosome 5, which contains 181 million base pairs and comprises nearly 6% of the human genome. Deletion of the p arm of chromosome 5 leads to Cri du chat syndrome, while deletion of the q arm or of chromosome 5 altogether is common in therapy-related acute myelogenous leukemias and myelodysplastic syndrome. |
|
Applications: |
ELISA, IHC |
|
Name of antibody: |
LSM11 |
|
Immunogen: |
Fusion protein of human LSM11 |
|
Full name: |
LSM11, U7 small nuclear RNA associated |
|
SwissProt: |
P83369 |
|
ELISA Recommended dilution: |
5000-10000 |
|
IHC positive control: |
Human tonsil and human thyroid cancer |
|
IHC Recommend dilution: |
25-100 |

購物車
幫助
021-54845833/15800441009
